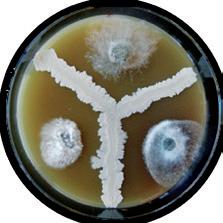

O φίλος σου στις προκλήσεις Μηδενικά υπολείμματα Βιολογική προστασία σε 75 καλλιέργειες Taegro®




Η υπεύθυνη λύση στην αντιμετώπιση μυκητολογικών ασθενειών, σε δενδρώδεις καλλιέργειες, κηπευτικά και αμπέλι χωρίς προβλήματα υπολειμμάτων. 3 Επαγωγή των φυσικών αμυντικών μηχανισμών του φυτού (SAR) Το TAEGRO® ενεργοποιεί τη φυσική άμυνα του φυτού παρεμποδίζοντας τις επιθέσεις των παθογόνων Υψηλή προστασία με τριπλό τρόπο δράσης 1 Ανταγωνισμός με τα παθογόνα πάνω στη φυλλική επιφάνεια Κατά τη διαδικασία ανάπτυξης, τα κύτταρα του TAEGRO® πολλαπλασιάζονται και έχουν την τάση να δημιουργούν αλυσίδες δημιουργώντας ένα στρώμα προστασίας πάνω στις φυτικές επιφάνειες 2 Απελευθέρωση μεταβολιτών που αναστέλλουν την ανάπτυξη παθογόνων Το όριο μιας αποικίας TAEGRO® Αναστολή ανάπτυξης παθογόνων από τους μεταβολίτες του TAEGRO® σε τρυβλίο petri
Πρόγραμμα συμβατικών
Πρόγραμμα συμβατικών προϊόντων Φ.Π. 2
Πρόγραμμα συμβατικών προϊόντων Φ.Π. 2 + Taegro®M.O.

Πηγή: Syngenta Ολλανδία NLBTZF9032017 Υψηλή αποτελεσματικότητα με μειωμένα υπολείμματα κοντά στη συγκομιδή Υψηλή συμβατότητα και προσαρμοστικότητα σε διάφορες συνθήκες ΡH και θερμοκρασίες Μεγάλη ευελιξία χρήσης 0 10 20 30 40 50 60 70 80 90 100 Aποτελεσματικότητα (%) Αψέκαστος Mάρτυρας Πρόγραμμα συμβατικών προϊόντων Φ.Π. 1 Πρόγραμμα συμβατικών προϊόντων Φ.Π. 1 + 37 γρ. Τaegro®
προϊόντων Φ.Π. 1 + 18.5 γρ. Τaegro®
7 πειραμάτων Προστασία καλλιέργειας αγγουριού από ωίδιο +48% υψηλότερη προστασία σε σχέση με τη συμβατική φυτοπροστασία στη δόση των 37 γρ. +43% υψηλότερη προστασία σε σχέση με τη συμβατική φυτοπροστασία στη δόση των 18,5 γρ. 0 10 20 30 40 50 60 70 80 90 100 Aποτελεσματικότητα (%) Αψέκαστος Mάρτυρας Πρόγραμμα συμβατικών προϊόντων Φ.Π. 1 Πρόγραμμα συμβατικών προϊόντων Φ.Π. 1 + 37 γρ. Τaegro® Πρόγραμμα συμβατικών προϊόντων Φ.Π. 1 + 18.5 γρ. Τaegro® Πρόγραμμα συμβατικών προϊόντων Φ.Π. 2 Πρόγραμμα συμβατικών προϊόντων Φ.Π. 2 + Taegro® Προστασία καλλιέργειας αγγουριού από ωίδιο σε σχέση με τη συμβατική φυτοπροστασία στη δόση των 37 γρ. σε σχέση με τη συμβατική φυτοπροστασία στη δόση των 18,5 γρ. pH 4 5 6 7 8 9 10 11 12 + + + + + 15° 20° 25° 30° 35° 40° 45° 50° 55° + ++ ++ +++ +++ ++ + Προσαρμοσμένο στα περισσότερα υδατικά διαλύματα, εδάφη και επιφάνειες των φυτών Τεχνικές συμβουλές ✔ Δεν λερώνει (βάφει) τις φυτικές επιφάνειες ✔ 0 ώρες διάστημα για συγκομιδή! ✔ Μεγάλη διάρκεια αποθήκευσης Ο μικρο-οργανισμός στο περιβάλλον επιβιώνει των περισσότερων συνθηκών. Όπως και όλα τα βακτήρια βρίσκει τις άριστες συνθήκες σε μέτριες προς υψηλές θερμοκρασίες + Ανάπτυξη - Επίκοιση 15° ≤ Άριστη T°C ≤ 45° Πλήρης συμβατότητα με ωφέλιμους οργανισμούς και βομβίνους PHI: 0
(Botrytis cinerea – Botryotinia fuckeliana
(Erysiphe necator)

BBCH 10-89 3 - 10 / 7 ημέρες Δαμασκηνιά, Κερασιά
Βοτρύτης (Botrytis cinerea)
Βοτρύτης (Botrytis cinerea )
Φραγκοστάφυλα* (κόκκινα, μαύρα ή άσπρα) (Υ), Φραγκοστάφυλα* (κόκκινα, πράσινα, κίτρινα) (Υ), Μύρτιλλα* (Υ), Σμέουρα*(ερυθρά και κίτρινα) (Υ, Μούρα-σμέουρα* (Υ) (Χρήση ήσσονος σημασίας)
Ωίδιο (Sphaerotheca morsuvae, Microsphaera grossulariae, Erysiphe suffulta, Sphaerotheca macularis)
BBCH 10-89 3 - 10/ 7 ημέρες
BBCH 10-89 3 - 10/ 7 ημέρες Φραγκοστάφυλα (κόκκινα, μαύρα ή άσπρα) (Y), Φραγκοστάφυλα (κόκκινα, πράσινα, κίτρινα) (Y), Μύρτιλλα (Y), Σμέουρα (ερυθρά και κίτρινα), Μούρα-σμέουρα (Y)
BBCH 10-99 3 - 10/ 7 ημέρες
Φραγκοστάφυλα* (κόκκινα, μαύρα ή άσπρα) (Θ), Φραγκοστάφυλα* (κόκκινα, πράσινα, κίτρινα) (Θ), Μύρτιλλα* (Θ), Σμέουρα* (ερυθρά και κίτρινα) (Θ), Μούρα-σμέουρα* (Θ) (Χρήση ήσσονος σημασίας)
Ακτινίδιο
Βοτρύτης (Botrytis cinerea) Ωίδιο (Sphaerotheca morsuvae, Microsphaera grossulariae, Erysiphe suffulta, Sphaerotheca macularis)
Γλοιοσπόριο* (Colletotrichum gloeosporioides, Colletotrichum acutatum, Colletotrichum clavatum) (Χρήση ήσσονος σημασίας)
Βοτρύτης* (Botrytis cinerea) (Χρήση ήσσονος σημασίας)

Φυτόφθορα (Phytophthora cambivora , Phytophthora cinnamomi), Έλκος καστανιάς (Cryphonectria parasitica)
Σκωρίαση Uromyces terebinthi (Pileolaria terebinthi ), Σεπτόρια (Septoria pistaciarum, Septoria pistacina), Έλκος κλαδίσκων (Fusicoccum sp.), Βοτρυοσφαίρια (Botryosphaeria dothidea), Φυτόφθορα
(Phellinus rimosus)
BBCH 10-99 3 - 10/ 7 ημέρες
BBCH 10-99 3 - 12/ 3 ημέρες Ελιά
BBCH 10-99 3 - 10/ 7 ημέρες
BBCH 10-99 3 - 10/ 7 ημέρες
Πεδίο Εφαρμογής Στόχος Xρόνος εφαρμογής Μέγ. αρ. εφ/γών / καλ/κή περ. Αμπέλι (Επιτραπέζια και οινοποιήσιμα σταφύλια) Βοτρύτης
), Ωίδιο
Καστανιά* (Χρήση ήσσονος σημασίας)
Φιστικιά* (Χρήση ήσσονος σημασίας)
(Phytophthora nicotianae var. parasitica, Phytophthora citrophthora, Phytophthora citricola), Ευτυπίωση (Eutypa lata), Βερτισιλλίωση (Verticillium dahliae ), Αρμιλλάρια (Armillaria sp), Ίσκα ή Πολυπορίαση
BBCH 10-99 3 - 10/ 7 ημέρες Φράουλα (Y+Θ) Βοτρύτης (Botrytis cinerea) BBCH 10-93 3 - 10/ 7 ημέρες (Y) 3 - 12/ 3 ημέρες (Θ) Τομάτα (Υ+Θ), Μελιτζάνα (Υ+Θ) Ωίδιο (Oidium neolycopersici, Leveillula taurica ), Αλτεναρίωση (Alternaria sp., Alternaria solani) BBCH 10-89 3 - 10/ 7 ημέρες (Υ) 3 - 12/ 3 ημέρες (Θ) Πιπεριά (Υ+Θ) Ωίδιο (Leveillula taurica), Αλτερναρίωση (Alternaria sp., Alternaria solani) BBCH 10-89 3 - 10/ 7 ημέρες (Υ) 3 - 12/ 3 ημέρες (Θ) Μπάμια* (Y) (Χρήση ήσσονος σημασίας) Ωίδιο (Golovinomyces cichoracearum) BBCH 10-99 3 - 10/ 7 ημέρες Βιολογική προστασία σε 75 καλλιέργειες Mε γιαπιστοποίηση χρήση γεωργίαβιολογικήστη απότη ΔΗΩ
(Υ)
(Erysiphe sp.)
Ωίδιο (Erysiphe sp.), Σκληρωτίνια (Sclerotinia sp.)
Βοτρύτης (Botrytis sp.)
(Erysiphe betae)
(Sclerotinia sclerotiorum)
Κηλίδωση
variabile)
(Botrytis squamosa
BBCH
3-10/ 7
BBCH 10-89 3 - 10/ 7
BBCH 10-99 3 - 10/ 7 ημέρες
BBCH 10-99 3 - 10/ 7 ημέρες
BBCH 10-99 3 - 10/ 7 ημέρες
BBCH 10-99 3 - 10/ 7 ημέρες
BBCH 10-99 3 - 10/ 7 ημέρες
BBCH 10-99 3 - 10/ 7 ημέρες
BBCH 10-99 3 - 10/ 7 ημέρες
BBCH 10-99 3 - 10/ 7 ημέρες
(Septoria apiicola)
BBCH 10-99 3 - 10/ 7 ημέρες
BBCH 10-99 3 - 10/ 7 ημέρες
BBCH 10-99 3 - 10/ 7 ημέρες Αρακάς* (Χρήση
ήσσονος σημασίας)
BBCH 10-99 3 - 10/ 7 ημέρες Ρεβίθι* (Y) (Χρήση
Ωίδιο (Erysiphe pisi)
BBCH 10-99 3 - 10/ 7 ημέρες Σπαράγγι* (Y) (Χρήση
(Mycosphaerella rabiei)
σημασίας) Βοτρύτης (Botrytis cinerea), Πενικιλίωση (Penicillium sp.)
σημασίας) Ωίδιο (Uncinula sp., Sphaerotheca sp., Phyllactinia sp., Podosphaera sp., Oidium sp., Microsphaera sp., Leveillula taurica, Leveillula spp., Erysiphe sp.)
Πράσο* (Y) (Χρήση
σημασίας)
Τεφρά σήψη (Botryotinia squamosa)
BBCH 10-99 3 - 10/ 7 ημέρες
BBCH 10-99 3 - 10/ 7 ημέρες Αγκινάρα* (Y) (Χρήση
BBCH 10-99 3 - 10/ 7 ημέρες
BBCH 10-99 3 - 10/ 7
Περονόσπορος (Bremia lactucae)
Σκληρωτινίαση (Sclerotinia sclerotiorum, Sclerotinia minor)
Πεδίο Εφαρμογής Στόχος Xρόνος εφαρμογής Μέγ. αρ. εφ/γών / καλ/κή περ. Αγγούρι (Y+Θ), Αγγουράκι για τουρσί (Y+Θ)), Κολοκυθάκι (Y+Θ), Πεπόνι (Y+Θ), Καρπούζι (Y+Θ), Κολοκύθα Ωίδιο [Podosphaera xanthii, Spaerotheca fuliginea, Golovinomyces cichoracearum (= Erysiphe cichoracearum)] BBCH 10-89 3 - 12/ 3 ημέρες (Θ) 3 - 10/ 7 ημέρες (Υ) Μαρούλι (Y+Θ), Σκαρόλες (πικρίδα) (Y+Θ)/πλατύφυλλα αντίδια (Y+Θ), Κατσαρά αντίδια (Y+Θ), Λυκοτρίβολο (Y+Θ), Ρόκα (Y+Θ)
10-89 Θ: 3-12/ 3 ημέρες Y:
ημέρες Μαρούλι (Y), Σκαρόλες (πικρίδα) (Y)/ πλατύφυλλα αντίδια (Y), Κατσαρά αντίδια (Y), Λυκοτρίβολο (Y), Ρόκα (Y)
ημέρες Ραδίκι* (Y) (Χρήση ήσσονος σημασίας) Ωίδιο
Αντίδι*(Y) (Χρήση ήσσονος σημασίας)
Σταμναγκάθι* (Y) (Χρήση ήσσονος σημασίας)
Παντζάρι*
(Χρήση ήσσονος σημασίας) Ωίδιο
Ραπανάκι* (Υ) (Χρήση ήσσονος σημασίας) Ωίδιο(Erysiphe cruciferarum.), Σκληρωτίνια
Σπανάκι* (Υ) (Χρήση ήσσονος σημασίας)
των φύλλων (Cladosporium
Βασιλικός* (Y), Σχοινόπρασο* (Y), Δρακόντιο/Εστραγκόν* (Y), Δάφνη* (Y), Μαϊντανός* (Y), Δενδρολίβανο* (Y)Φασκόμηλο* (Y), Θυμάρι* (Y) (Χρήσεις ήσσονος σημασίας) Σκληρωτίνια (Sclerotinia sp.), Βοτρύτης
, Botrytis allii )
Μαϊντανός* (Y) (Χρήση ήσσονος σημασίας) Ωίδιο (Erysiphe sp.)
Σέλινο* (Y), Σέλερυ* (Y) (Χρήση ήσσονος σημασίας) Σεπτορίωση
Άνηθος* (Y) (Χρήση ήσσονος σημασίας) Σκληρωτίνια (Sclerotinia sp.), Ωίδιο (Erysiphe heraclei), Σεπτόρια (Septoria petroselini)
Φασόλι (Y) Ωίδιο* (Erysiphe polygoni ) (Χρήση
ήσσονος σημασίας)
ήσσονος σημασίας) Ασκοχύτωση
ήσσονος
ήσσονος
ήσσονος
Κρεμμύδι (Y) Βοτρύτης* (Botrytis cinerea) (Χρήση ήσσονος σημασίας)
ημέρες Παρατηρήσεις: 1. Η δόση και ο όγκος ψεκαστικού υγρού εξαρτάται από την ένταση της προσβολής, το στάδιο ανάπτυξης της καλλιέργειας και τις συνθήκες περιβάλλοντος. 2. Οι εφαρμογές είναι προληπτικές, όταν οι συνθήκες είναι ευνοϊκές για την ανάπτυξη των ασθενειών. 3. Να το εφαρμόζετε κατά προτίμηση το απόγευμα, για να αποφευχθεί η έκθεση στην ακτινοβολία UV. 4. Τα καλύτερα αποτελέσματα επιτυγχάνονται σε θερμοκρασίες 15 – 30° C. Η δράση του ελαττώνεται σημαντικά σε θερμοκρασίες > 40° C. 5. Μην το εφαρμόζετε όταν αναμένεται βροχή ή όταν τα φύλλα της καλλιέργειας είναι ακόμη βρεγμένα. 6. Συνολικά το μέγιστο αριθμό εφαρμογών ανά καλλιεργητική περίοδο είναι 10 στον αγρό και 12 στο θερμοκήπιο. 7. Να ακολουθούνται στις περιοχές που εφαρμόζονται, οι συστάσεις από τα προγράμματα Γεωργικών Προειδοποιήσεων. 8. Η χρήση του σκευάσματος μπορεί να ενταχθεί σε προγράμματα ολοκληρωμένης καταπολέμησης. 9. Η αποτελεσματικότητα του προϊόντος μπορεί να διαφοροποιηθεί ανάλογα με τις περιβαλλοντικές συνθήκες. 10. Δεν έχει ελεγχθεί η φυτοτοξικότητα του σκευάσματος στις εθνικές ποικιλίες Σουλτανίνα και Κορινθιακή σταφίδα. * Για τις χρήσεις ήσσονος σημασίας δεν έχει τεκμηριωθεί η αποτελεσματικότητα και δεν έχει γίνει έλεγχος για ενδεχόμενες αρνητικές επιπτώσεις από τη χρήση του σκευάσματος. Για την χρήση του σκευάσματος στις καλλιέργειες αυτές ο κάτοχος της άδειας δεν φέρει ευθύνη για πιθανές αποτυχίες που αφορούν την αποτελεσματικότητα ή τη φυτοτοξικότητα από τη χρήση του σκευάσματος. • Δόση: 18,5 - 37 γρ./στρέμμα Προληπτικοί ψεκασμοί όταν οι συνθήκες είναι ευνοϊκές για την ανάπτυξη των ασθενειών


Syngenta Hellas Μονοπρόσωπη Α.Ε.Β.Ε. Ανθούσα Αττικής, TK 153 49, τηλ.: 210 66 66 612-3 ΒΙ.ΠΕ.Θ., Σίνδος, Θεσσαλονίκη, τηλ.: 2310 796 940-3, 2310 798 595 www.syngenta.gr Ακολουθήστε μας: @syngentahellas Ημερομηνία έκδοσης παρόντος Αύγουστος 2022 Αριθμός Άδειας Διάθεσης στην Αγορά (ΑΑΔΑ): 60884 / 28-08-2019 Τα φυτοπροστατευτικά προϊόντα να χρησιμοποιoύνται με ασφαλή τρόπο. Να διαβάζετε πάντα την ετικέτα και τις πληροφορίες σχετικά με το προϊόν πριν από τη χρήση, καθώς και τις προειδοποιητικές φράσεις και σύμβολα. Mπαίνουμε σε νέα εποχή! Oλοκληρωμένα προγράμματα φυτοπροστασίας Προστασία από μυκητολογικές ασθένειες με την εγγύηση της Syngenta Διατηρεί τις ασθένειες σε χαμηλή ένταση μέχρι την συγκομιδή Μηδενικά υπολείμματα